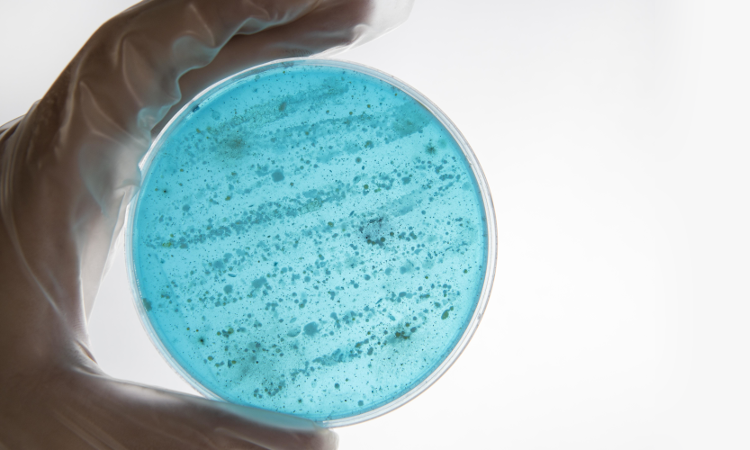
Новое направление работы: оценка антибактериальной и противогрибковой активности веществ различной природы

+7* (*81*2)* 4*99*–1*5–*00
Адрес
197022, Санкт-Петербург, ул. проф. Попова 15/17
Режим работы
Пн. – Пт.: с 9:00 до 18:00
Запись онлайн
Телефоны
Адрес
197022, Санкт-Петербург, ул. проф. Попова 15/17
Режим работы
Пн. – Пт.: с 9:00 до 18:00
-
- 197022, Санкт-Петербург, ул. проф. Попова 15/17
- Пн. – Пт.: с 9:00 до 18:00